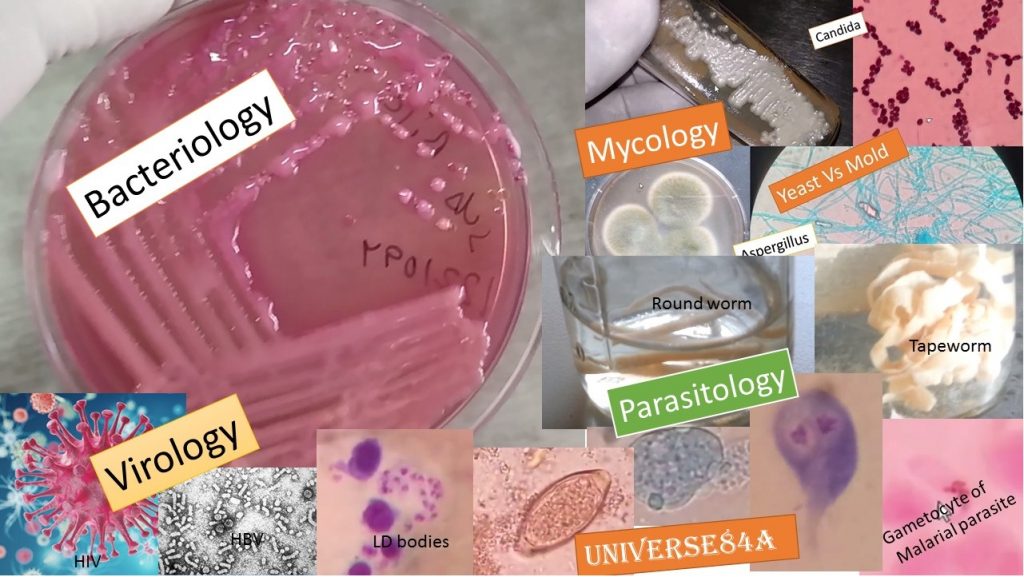
classification of Microorganisms

Microorganisms Classification: Introduction, Types and Significance
Introduction of Microorganisms
Microorganisms are minute living organisms those only observable under a microscope. They are bacteria, viruses, fungus, and parasites( protozoa and helminths). Helminths are metazoa i.e. multicellular organisms even they are part of microorganisms because some structures ( egg or larvae) are only observable under the microscope. All organisms are seen under a light compound microscope except viruses. Viruses are the smallest organisms (20 nm -200 nm). This is the reason to observe need an electron microscope.
# Heavy load of parasites in stool|| Stool microscopic examination|| Trichomonas hominis as shown below-
#Live bacteria under the Microscope: Bacteria are motile due to having flagella. In these microscopic fields, you can see some bacteria are moving due to possessing flagellum/flagella whereas some are non-motile due to not having flagella or maybe killed as shown below-
# Fungus, Aspergillus fumigatus Colony on SDA and LPCB tease mount under the microscope as shown below-
Microbial taxonomy
- Taxonomy is the branch of biological classification.
- In Greek: taxas-order/arrangement
- nomos-science or law
Consists of these separate but intermediate parts
- Classification: orderly arrangement of organisms into groups. A group of units is known as a taxon (plural taxa).
- Nomenclature: Assignment of names to taxa.
- Identification: Determination of taxon to which an isolate belongs.
Importance of taxonomy
- It permits the organization of huge amounts of information about microorganisms.
- Permits organisms in useful groups with precise names that permit effective communication between investigators.
- Essential for the correct identification of organisms.
Development of taxonomy
- Aristotle (June 19, 384 BC-March 7,322 BC)
- From Greece
- Categorized organisms into two groups i.e. animal and plant and classification based on appearance.
- Carolus Linnaeus (1735)
- Proposed two-kingdom system of classification based on morphological characteristics.
- Plantae and Animalia
- However, this classification had obvious difficulties, including the problem of placing fungi, protists, and prokaryotes. Also placing the organism like euglena and that is why modifications were going on.
Types of classification of microorganisms
Two kingdom systems of classification: It consists of Plantae and Animalia.
Three kingdom system of classification: It is also called Ernest Haeckel classification (1866). He was a German Biologist, naturalist, and philosopher. He was the first to coin the term “Protista”. It holds Protista, Plantae and Animalia. Placed bacteria in the kingdom Protista.
Two Empire system
- Proposed by Edward Chatton, 1937.
- Empire is actually a rank above kingdom, a superkingdom.
- Empire-prokaryotes and eukaryotes.
Four kingdom system of classification
In 1938, Herbert F. Copeland, proposed this system of classification, moving the prokaryotic group bacteria and blue-green algae into separate kingdom Monera. Kingdom Monera consists of prokaryotes i.e. bacteria plus blue-green algae and other remaining are Protista ( single celled eukaryotes), Plantae, and Animalia.
Five kingdom system of classification
- Proposed by Robert Whittaker in 1969.
- The system was widely used for three decades and remains popular today.
- Empire -prokaryota and Eukaryota whereas kingdom consists Monera, Protista, Plantae, Fungi, and Animalia.
Six kingdom system of classification
In 1977, Woese et. al. proposed this kingdom system dividing monera into eubacteria and archaebacteria and remaining the same.
Three domain System
- Carl Woese and colleagues divided prokaryotes into domains Archea and Bacteria on the basis of nucleotide sequences in Ribosomal RNA. It includes Archaea, Bacteria, Eukarya.
- The bacterial domain includes five main groups, proteobacteria, chlamydia, Spirochetes, Cyanobacteria, and Gram-positive bacteria.
- Woese’s three-domain system based upon genetic relationships divides life into 23 main divisions, all incorporated within the three-domain.
Bergey’s Manual of Determinative bacteriology
Bergey’s Committee was formed in 1923 by David Bergey (bacteriologist, University of Pennsylvania) and his colleagues who published a classification of bacterial species Known as Bergey’s manual of determinative bacteriology.
Baltimore classification
- ICTV (International Committee for Taxonomy of Viruses) classification
- Hawksworth classification
- Levine et.al. classification
Taxonomical Hierarchy
- Life
- Domain
- Kingdom
- Phylum
- Class
- Order
- Family
- Genus
- Species
Note: Remember as ‘LDKP COF GS’.
Specific classification for bacteria
- 3 Domain classification
- Bergey’s Manual of Systemic bacteriology
Specific classification for virus
- Baltimore classification
- ICTV (International Committee for Taxonomy of Viruses) classification
Key: ICTV stands for the International Committee for the taxonomy of viruses
Specific classification for fungus
- Hawksworth classification
Specific classification for parasites
- Levine et.al. classification
Further Readings
- Medical Mycology. Editors: Emmons and Binford, 2nd ed 1970, Publisher Lea and Febiger, Philadelphia.
- Rippon’s JW: Medical Microbiology. The pathogenic fungi and the Pathogenic Actinomycetes. 3rd ed 1988 Publisher WB Saunder co, Philadelphia.
- Clinical Microbiology Procedure Handbook Vol. I & II, Chief in editor H.D. Isenberg, Albert Einstein College of Medicine, New York, Publisher ASM (American Society for Microbiology), Washington DC.
- A Text-Book of Medical Mycology. Editor: Jagdish Chander. Publication Mehata, India.
- Practical Laboratory Mycology. Editors: Koneman E.W. and G.D. Roberts, 3rd ed 1985, Publisher Williams and Wilkins, Baltimore.
- Topley & Wilsons Medical Mycology. Editors: M.T. Parker & L.H. Collier, 8th ed 1990, Publisher Edward Arnold publication, London.
- Textbook of Diagnostic Microbiology. Editors: Connie R. Mahon, Donald G. Lehman & George Manuselis, 3rd edition2007, Publisher Elsevier.
- Mackie and Mc Cartney Practical Medical Microbiology. Editors: J.G. Colle, A.G. Fraser, B.P. Marmion, A. Simmous, 4th ed, Publisher Churchill Living Stone, New York, Melborne, Sans Franscisco 1996.
- Bailey & Scott’s Diagnostic Microbiology. Editors: Bettey A. Forbes, Daniel F. Sahm & Alice S. Weissfeld, 12th ed 2007, Publisher Elsevier.
- Medical Parasitology by Abhay R. Satoskar, Gary L. Simon, Peter J. Hotez and Moriya Tsuji
- Atlas of Medical Helminthology and protozoology -4th edn -P.L. Chiodini, A.H. Moody, D.W. Manser
- Merkell and vogue’s medical parasitology 9th edition.
- Parasitology: 12th edition By K. D. Chatterjee
- Fields Virology Vol I & II, Editor in Chief: David M. Knipe & Peter M. Howley, Asso editors: Diane E. Griffin, Robert A. Lamb, Malcolm A. Martin, Bernard Roizman & Stephen E. Straus, 5th ed 2007, Publisher Lippincott Williams & Wilkins, Wolters Kluwer Health, USA.
